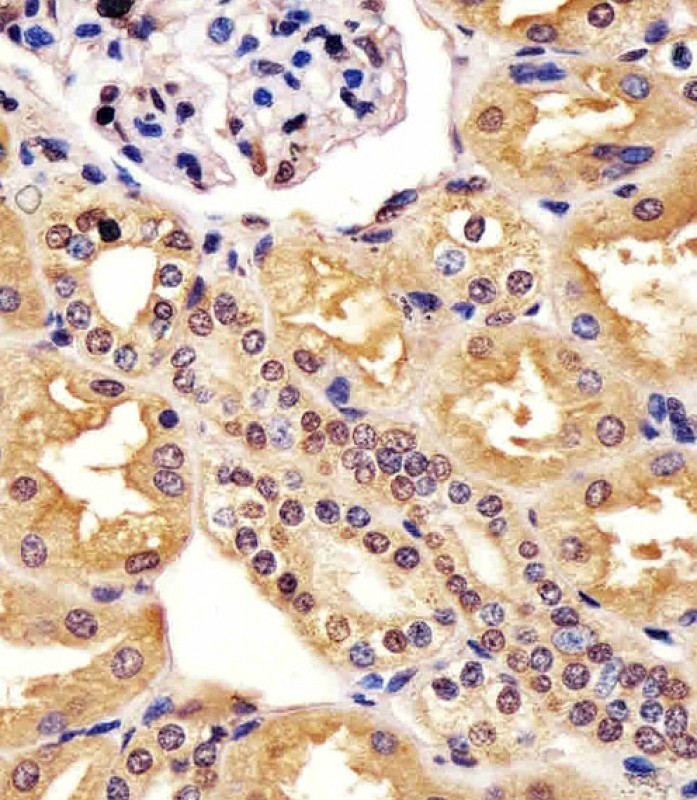

-
分类: 科研抗体货号: P33208别名: Protein L-Myc, Class E basic helix-loop-helix protein 38, bHLHe38, Protein L-Myc-1, V-myc myelocytomatosis viral oncogene homolog, MYCL, BHLHE38, LMYC, MYCL1应用: WB反应种属: Human, Mouse
-
分类: 科研抗体货号: P33183别名: LIM domain only protein 7, LMO-7, F-box only protein 20, LOMP, LMO7, FBX20, FBXO20, KIAA0858应用: WB反应种属: Human
-
分类: 科研抗体货号: P33206别名: Uncharacterized protein C17orf80, Cell migration-inducing gene 3 protein, Human lung cancer oncogene 8 protein, HLC-8, C17orf80应用: WB反应种属: Human
-
分类: 科研抗体货号: P33182别名: Stromal cell-derived factor 1, SDF-1, 12-O-tetradecanoylphorbol 13-acetate repressed protein 1, TPAR1, C-X-C motif chemokine 12, Pre-B cell growth-stimulating factor, PBSF, Thymic lymphoma cell-stimulating factor, TLSF, Cxcl12, Sdf1应用: WB反应种属: Human, Mouse, Rat
-
分类: 科研抗体货号: P33205别名: Protein SSX2, Cancer/testis antigen 52, CT52, Synovial sarcoma, X breakpoint 2, Tumor antigen HOM-MEL-40, SSX2, SSX2A应用: WB反应种属: Human, Mouse
-
分类: 科研抗体货号: P33181别名: Protein Jumonji, Jumonji/ARID domain-containing protein 2, Jarid2, Jmj应用: WB反应种属: Mouse
-
分类: 科研抗体货号: P33203别名: Semaphorin-4G, SEMA4G, KIAA1619应用: WB反应种属: Human, Mouse
-
分类: 科研抗体货号: P33180别名: D-amino-acid oxidase, DAAO, DAMOX, DAO, DAO, DAMOX应用: WB反应种属: Human, Mouse, Rat
-
分类: 科研抗体货号: P33200别名: Mastermind-like protein 2, Mam-2, MAML2, KIAA1819应用: WB,IHC反应种属: Human
-
分类: 科研抗体货号: P33199别名: CXXC-type zinc finger protein 1, CpG-binding protein, PHD finger and CXXC domain-containing protein 1, Cxxc1, Cgbp, Pccx1应用: WB反应种属: Human, Mouse, Rat

鄂公网安备42018502007531号
鄂公网安备42018502007531号

